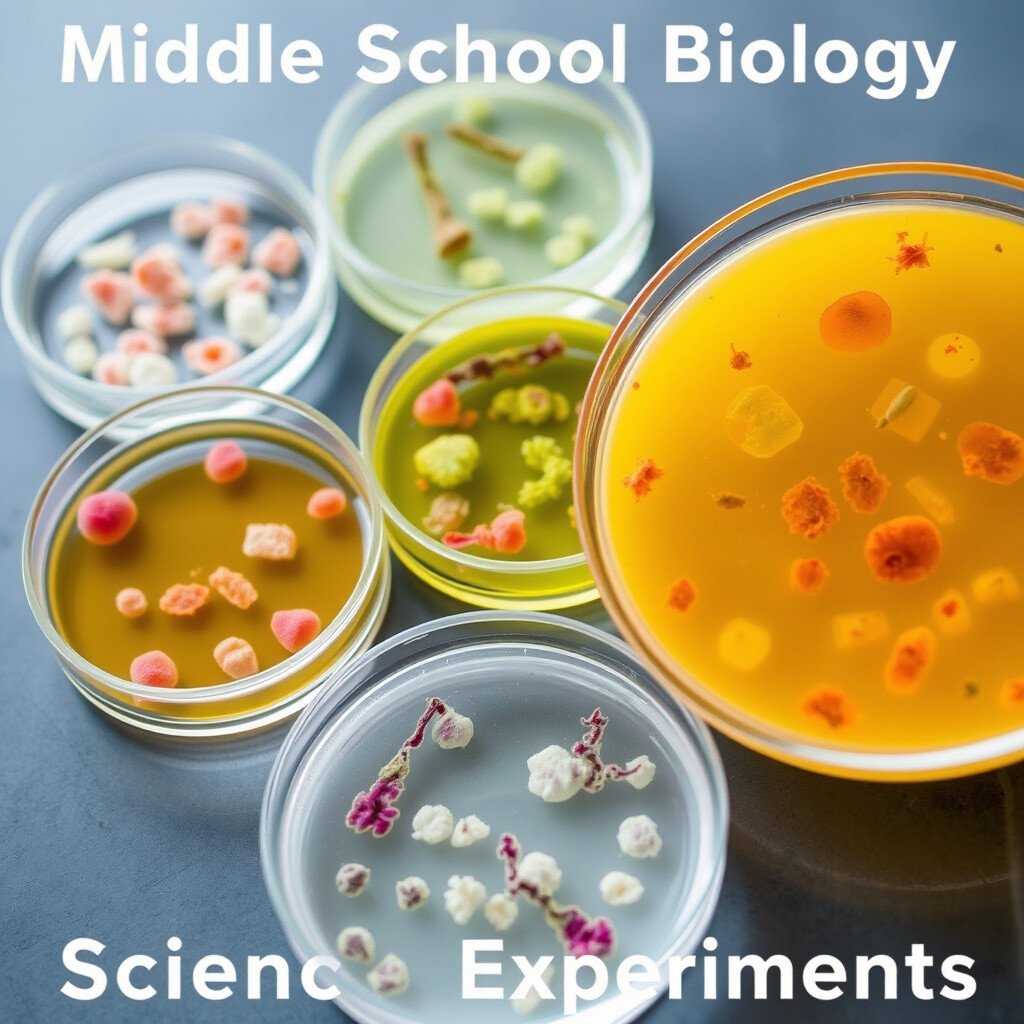

Biology can be as exciting as a mystery waiting to be unraveled. Imagine turning your curiosity into a project that not only fascinates but also educates those around you.
1. The Magic of Plant Growth with Music

Ever wondered if your plants enjoy a good tune? Set up a fun experiment to see if music affects the growth of plants. Play different genres like classical, rock, or pop to separate plant groups and observe their growth over several weeks.
It’s like running a concert for your plants! This experiment is unique because it connects biology with art. Watching plants dance to the rhythm of the music can be both amusing and educational. All you need are some seeds, pots, and a speaker.
Try personalizing by choosing your favorite songs. The cost is low since you likely already have music and pots at home. Let your plants rock out!
2. Colorful Chemistry with Red Cabbage

Red cabbage isn’t just for salads; it can be a magical indicator of acidity and alkalinity. Use it to create a vibrant pH indicator that changes color in different solutions, like lemon juice or baking soda.
This idea is a visual treat and a great way to learn about acids and bases. Watching the colors change feels like performing a magic trick. Plus, it’s super easy and inexpensive!
Grab a cabbage, a blender, and some common kitchen supplies. It’s a low-cost project that is sure to catch eyes at the science fair.
3. The Secret Life of Mold

Have you ever seen mold growing on bread or fruit and wondered why? Investigate how different conditions affect mold growth by using bread slices in various environments, like the fridge or a sunny window.
This project is perfect for those curious about fungi. It’s fascinating to see how quickly mold can appear in the right conditions. You’ll need some bread, a few containers, and a bit of patience.
Make it unique by testing different types of bread or adding variables like moisture. It’s a cheap and eye-opening experiment!
4. The Power of Photosynthesis

Explore how plants make their food through photosynthesis by creating a mini greenhouse. Use clear containers and different light sources to see how plants respond.
This idea brings the process of photosynthesis to life in a hands-on way. Watching plants thrive or struggle under different lights can be surprising and enlightening.
Use household items like plastic bottles and lamps. The cost is minimal, and the insights are invaluable!
5. Fingerprint Forensics

Everyone’s fingerprints are unique, just like a snowflake. Create an experiment to collect and compare fingerprints from family or friends using simple materials like tape and powder.
It’s a thrilling way to learn about individuality and forensic science. You’ll feel like a detective solving a mystery!
Personalize by testing different surfaces or powders. This project is very affordable and sparks curiosity about human biology.
6. Eggshell Geodes

Turn eggshells into crystal geodes by soaking them in a supersaturated solution of salt or sugar. Watch as crystals form and sparkle over time.
This experiment is a dazzling combination of biology and geology. The process is like growing your own little gems at home!
It’s easy to customize with food coloring for added flair. The materials are common household items, making it an inexpensive project with a wow factor.
7. Dancing Raisins

Raisins can dance in a glass of soda, thanks to carbonation. Set up this simple experiment to see how gas bubbles make raisins move in the liquid.
It’s a fun way to understand buoyancy and gas properties. Watching raisins rise and fall is both entertaining and educational.
Try different sodas or dried fruits for variety. This project costs next to nothing and is sure to be a hit!
8. DNA Extraction from Strawberries

Did you know you can see DNA with the naked eye? Extract DNA from strawberries using simple kitchen ingredients like dish soap and salt.
This experiment is like uncovering the building blocks of life. It’s fascinating to see strands of DNA appear before your eyes.
It’s affordable and easy to perform with household materials. Impress your friends with your genetic know-how!
9. The Effect of Sugar on Yeast

Explore how sugar affects yeast growth by setting up an experiment with sugar water and different yeast types. Watch bubbles form as the yeast ferments.
This project is a bubbling introduction to microbiology. It’s exciting to see how different sugars impact yeast activity.
Personalize by trying different temperatures or sugar types. It’s low-cost, using everyday ingredients found in your kitchen.
10. Biodegradable Plastic from Corn Starch

Create eco-friendly plastic using corn starch and vinegar. Mold it into shapes and see how it compares to conventional plastics.
This experiment is perfect for those interested in sustainability. Making your own biodegradable plastic is both fun and environmentally conscious.
The materials are cheap and accessible, showing that science can help save the planet. Customize by adding colors or scents!
11. The Fascinating World of Ant Farms

Ants are tiny creatures with complex societies. Create an ant farm to observe their behavior and how they build tunnels.
This project is a window into the world of insects. Watching ants work together is both mesmerizing and informative.
Use a clear container and some soil to start. It’s an affordable way to learn about ecosystems and teamwork.
12. Water Filtration Magic

Design a homemade water filter using sand, gravel, and charcoal. Test its effectiveness by filtering dirty water and observing the results.
This experiment shows the importance of clean water. Creating a filter is like performing a magic trick that transforms dirty water into something drinkable.
It’s simple and cheap, with materials you can find around the house. Personalize by trying different filter layers or materials.
13. The Mysterious Life of Sea Monkeys

Sea monkeys are tiny brine shrimp that come to life in water. Raise them from eggs and observe their fascinating lifecycle.
This project is like having your own mini aquarium. Watching them grow and swim is both relaxing and educational.
Sea monkey kits are inexpensive and provide endless entertainment. Customize by adding decorations to their habitat.
14. The Vibrant World of Chromatography

Separate colors in markers or leaves using chromatography. Create a beautiful display of colors as you learn about pigments.
This experiment is a colorful introduction to chemistry and biology. The process is like revealing hidden rainbows in everyday items.
It’s cheap, with materials like coffee filters and rubbing alcohol. Personalize by testing different plants or inks.
15. The Art of Bacterial Cultures
Grow bacteria from different surfaces in petri dishes using agar. Observe the growth patterns and learn about cleanliness.
This project is a hands-on way to understand microbiology. It’s fascinating to see what grows from various places around your home.
Petri dishes and agar are affordable and easily available online. Customize by testing different locations or cleaning products.
16. The Electric Power of Potatoes

Turn potatoes into a simple battery by inserting copper and zinc electrodes. Light up an LED and learn about chemical energy.
This experiment is a playful way to explore energy conversion. Who knew potatoes could power a light bulb?
It’s low-cost, using common household items. Try using different fruits or vegetables for a twist!
17. Investigating Plant Tropisms

Study how plants respond to light, gravity, or touch by setting up simple experiments with seedlings and light sources.
This project is a captivating look at plant behavior. It’s amazing to see how they move and grow in response to their environment.
Use inexpensive seeds and a lamp to start. Personalize by testing different types of stimuli or plants.
18. The Mystery of Owl Pellets

Dissect owl pellets to discover what owls eat. Identify bones and other materials to learn about their diet and hunting habits.
This experiment is like solving a nature puzzle. It’s intriguing to see what these nocturnal hunters consume.
Owl pellets are affordable and available online. Customize by creating a chart of your findings.